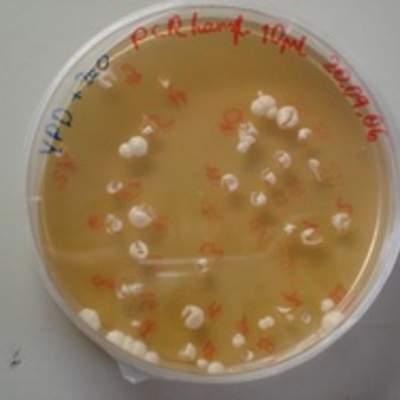
Levaduras en placa Levaduras en placa

Grupo: Título del recurso
Priorización 2023-2025: Aprendizajes Basales
CN05 OA 07
Investigar e identificar algunos microorganismos beneficiosos y dañinos para la salud (bacterias, virus y hongos), y proponer medidas de cuidado e higiene del cuerpo.
Clasificaciones
Textos Escolares oficiales 2023

Ciencias Naturales 5° Básico, Santillana, Texto del estudiante

Ciencias Naturales 5° Básico, Santillana, Cuaderno de actividades

Ciencias Naturales 5° básico, Santillana, Guía didáctica del docente Tomo 1

Ciencias Naturales 5° básico, Santillana, Guía didáctica del docente Tomo 2
Actividades de apoyo pedagógico

Plan de apoyo compartido: Ciencias Naturales 5° básico, Cuerpo humano y salud
Material didáctico
Evaluaciones del programa

Evaluación Programa - OA07 - Medidas de prevención de contagio
Indicadores
Indicadores Unidad 3
- Describen el efecto beneficioso de algunas bacterias en el organismo (por ejemplo competencia con bacterias patógenas, evitando su colonización).
- Investigan los beneficios de algunos hongos comestibles.
- Identifican agentes dañinos para la salud (bacterias, virus y hongos).
- Describen cómo algunas enfermedades son producidas por el ingreso y multiplicación de agentes infecciosos en nuestro organismo.
- Distinguen las enfermedades producidas por agentes infecciosos (virus y bacterias), de otros tipos de enfermedades.
- Explican el uso de desinfectantes (ejemplo: cloro, alcohol, povidona yodada, agua oxigenada), como sustancias que eliminar gran parte de los agentes infecciosos y permiten prevenir enfermedades.
- Mencionan diversas acciones, como, lavarse las manos, cubrirse la boca al estornudar, lavar los alimentos, etc., que permiten prevenir el contagio de enfermedades infecto contagiosas.
Modifica o crea tu evaluación seleccionando las preguntas disponibles para este objetivo que te interesen. Solo debes hacer clic en el botón "Agregar pregunta".
Cada vez que sumes una pregunta, aumentará en una unidad el botón que flota al costado derecho de esta página. Si lo presionas verás el listado de preguntas de la evaluación que estás creando o modificando.
Si deseas buscar más preguntas por nivel, asignatura, eje, unidad, objetivo o un término, utiliza el buscador de Arma tu evaluación
Preguntas
Ejemplos de microorganismos patógenos
Enunciado
Existe una amplia diversidad de microorganismos, algunos son beneficiosos para nuestra salud y otros causan enfermedades siendo catalogados como patógenos. A continuación, se presentan tres patologías asociadas a microorganismos patógenos y para cada una debes indicar el nombre del microorganismo responsable y los síntomas que puede presentar la persona infectada.
1. Cólera
2. Pie de atleta
3. COVID-19
Respuesta
| Enfermedad: Cólera |
Microorganismo responsable:
|
Síntomas:
|
| Enfermedad: Píe de atleta |
Microorganismo responsable:
|
Síntomas:
|
| Enfermedad: Coronavirus |
Microorganismo responsable:
|
Síntomas:
|